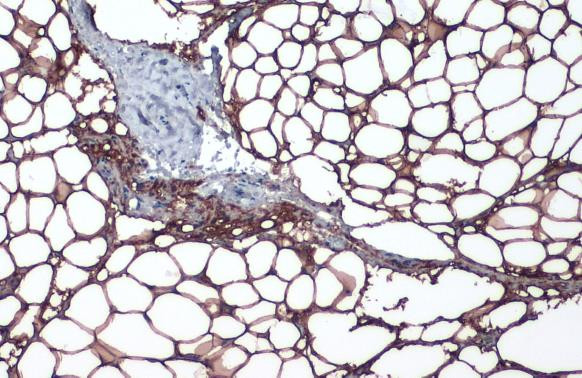
Perilipin 1 Antibody in Immunohistochemistry (Paraffin) (IHC (P))

Search
Invitrogen
Perilipin 1 Polyclonal Antibody
{{$productOrderCtrl.translations['antibody.pdp.commerceCard.promotion.promotions']}}
{{$productOrderCtrl.translations['antibody.pdp.commerceCard.promotion.viewpromo']}}
{{$productOrderCtrl.translations['antibody.pdp.commerceCard.promotion.promocode']}}: {{promo.promoCode}} {{promo.promoTitle}} {{promo.promoDescription}}. {{$productOrderCtrl.translations['antibody.pdp.commerceCard.promotion.learnmore']}}
图: 1 / 3
Perilipin 1 Antibody (PA5-85627) in IHC (P)



Please note: We are reviewing Western blot images included in the antibody testing data in our catalog, including those provided by third parties. Unless expressly labeled or annotated as “raw-unedited”, Western blot images included in the antibody testing data in our catalog may have been edited, optimized or otherwise adjusted for presentation.
产品信息
PA5-85627
种属反应
宿主/亚型
分类
类型
抗原
偶联物
形式
浓度
规格
纯化类型
保存液
内含物
保存条件
运输条件
RRID
产品详细信息
Keep as concentrated solution.
Predicted reactivity: Mouse (92%), Rat (92%), Pig (92%), Sheep (94%), Bovine (94%).
Positive Control: THP-1, mouse adipose.
Store product as a concentrated solution. Centrifuge briefly prior to opening the vial.
靶标信息
Adipose tissue is an energy reserve in animals and is strictly regulated in nondomestic species. Adipose cells produce and secrete numerous physiologically important proteins, such as lipoprotein lipase (LPL), leptin, adipocyte complement related protein of 30 kDa (Acrp30), resistin, and perilipin. Perilipin is an intracellular neutral lipid droplet protein that is hormonally regulated. This protein is localized exclusively to the surface of lipid droplets. In response to lypotic stimuli, perilipin is phosphorylated by protein kinase A. Once activated, perilipin has inhibitory affects upon hormone-sensitive lipase (HSL), a protein that mediates the hydrolysis of triacylglycerol, the major form of stored energy in the body. Perilipin expression is limited to adipocytes and steroidogenic cells. There are currently two known isoforms, Perilipin A and B. Both of these proteins are encoded by a single-copy gene and are the result of differential splicing events.
仅用于科研。不用于诊断过程。未经明确授权不得转售。
篇参考文献 (0)
生物信息学
蛋白别名: Lipid droplet-associated protein; perilipin; Perilipin A; perilipin B; Perilipin-1
基因别名: 6030432J05Rik; PERI; PLIN; PLIN1
UniProt ID: (Mouse) Q8CGN5
Entrez Gene ID: (Mouse) 103968